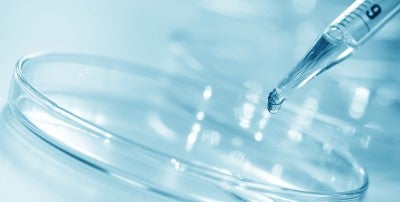
Lehigh Valley Topper Cancer Institute Is Now Offering a Pioneering Rectal Cancer Trial

In June 2022, Maged Khalil, MD, with Lehigh Valley Topper Cancer Institute, started receiving calls from patients about a clinical trial for rectal cancer that was headline news.
The results of the 14-person study at Memorial Sloan Kettering Cancer Center (MSK) of an immunotherapy checkpoint inhibitor drug were remarkable. All the participating individuals, who had stage 2 or 3 rectal adenocarcinoma tumors with a specific genetic makeup (deficient DNA mismatch repair protein, or dMMR), had a complete clinical response, with no evidence of tumor on MRI. About 5%–10% of rectal cancers are microsatellite instability-high (MSI-H).
“These results were revolutionary,” Khalil says. “It signaled a paradigm shift in how we might treat rectal cancer.”

